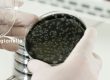
1 (1)

Mikroplastika je zbirni naziv za čestice različitih plastičnih materijala koje su manje od 5 mm. Proizvodi se procesima abrazije i razlaganja plastike, ali se takođe dodaje proizvodima za ličnu negu i čišćenje. Mikroplastika je sada svuda i ulazi u životnu sredinu i, naravno, u ciklus vode na različite načine. Prema studiji VVF-a iz 2019., mi unosimo oko 5 grama mikroplastike nedeljno – što je težina kreditne kartice. Pošto je mikroplastika svuda, nemoguće je ne progutati mikroplastiku. Udišemo većinu. Male plastične čestice takođe unosimo kroz hranu i vodu za piće.
Mikroplastika
Istraživači su sada otkrili mikroplastiku u vodi širom sveta: u jezerima, rekama, okeanima, u flaširanoj vodi, kao i u vodi iz slavine. Velika studija NVO „Orb Media“ u saradnji sa Univerzitetom Minesote u SAD o mikroplastici u uzorcima vode iz slavine iz celog sveta je već 2017. godine pokazala da je više od 80 odsto uzoraka vode analiziranih u to vreme sadržao mikroplastiku, takođe u nemačkim uzorcima – čak i u veoma malim količinama. Budući da se u Nemačkoj oko jedne trećine vode za piće dobija iz površinskih voda (1,7 milijardi kubnih metara), nije iznenađujuće da voda za piće može da sadrži i mikroplastiku. Inače, veći je udeo u flaširanoj vodi (plastici i staklu), što je verovatno povezano sa ambalažom i zatvaračem.
Da li je mikroplastika u vodi za piće štetna po zdravlje?
Prema SZO, mikroplastika – kako stvari sada stoje – nije štetna po zdravlje. Međutim, u ovo je teško poverovati. Još uvek je premalo studija na temu mikroplastike u vodi za piće i njenog dejstva.
Stručnjaci pretpostavljaju da telo izlučuje čestice veće od 150 mikrometara. Ali da li se ovo odnosi i na mnogo manje mikroplastične čestice još nije dovoljno istraženo. Takođe je nejasno kakve zdravstvene posledice imaju nakupine mikroplastike u telu. Studija SZO vidi tri izvora opasnosti za ljude od mikroplastike u vodi:
Prvo, same plastične čestice, kada se akumuliraju u telu i koje telo proguta absorpcijom.
Drugo, hemijske supstance (npr. aditivi kao što je BPA) koje čestice ispuštaju u telo ili koje absorbuju
Biofilmovi koji se talože na česticama i na kojima se mogu akumulirati toksini.
Unošenje mikroplastike u ljudsko telo može se desiti absorpcijom manjih čestica kroz creva. Mikroplastika je već otkrivena u ljudskoj krvi i plućima pacijenata. Istraživanja do sada ne znaju tačan odgovor na pitanje tačnih efekata mikroplastike na ljudski organizam. Međutim, dosadašnji nalazi iz oblasti istraživanja mora i životne sredine su dramatični. Ribe i drugi stanovnici mora absorbuju mikroplastiku i kroz hranu i kroz filtriranje morske vode. Oni su oštećeni ili barem oslabljeni plastikom i supstancama koje na nju prianjaju. Pored fizioloških poremećaja, posledice su povećano formiranje tumora i znatno veći mortalitet morskih životinja.
Naučnici sa Univerziteta u Marburgu su 2021. godine koristili eksperimente na ćelijskim kulturama i miševima da bi istražili kako mikroplastika utiče na imune ćelije i krvne sudove. Rezultati istraživanja su pokazali da mikroplastika može izazvati inflamatorne reakcije u tkivu. Rezultati studije takođe sugerišu da mikroplastika takođe može biti faktor rizika za kardiovaskularne bolesti.
Iako još uvek nema ubedljivih naučnih dokaza o tačnim efektima mikroplastike na ljudsko zdravlje, ljudi ne žele da imaju takve strane supstance u sopstvenom telu. Zbog toga bi mikroplastika generalno trebalo da bude uključena kao faktor rizika u proceni kvaliteta vode.

Imate još pitanja ?